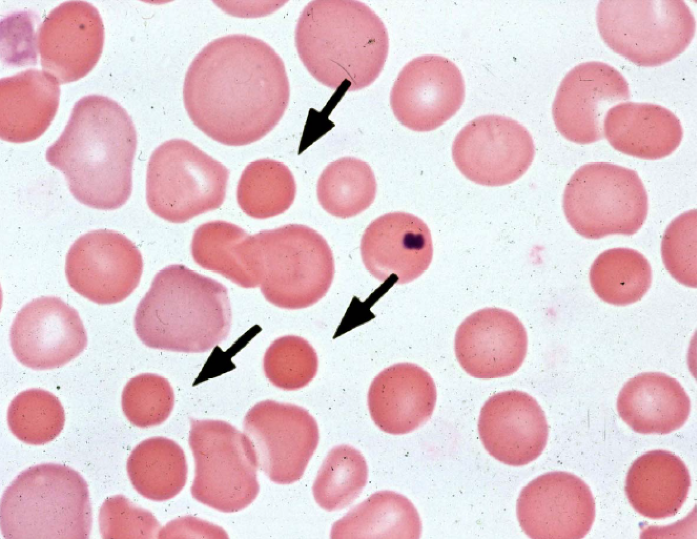

Sferocitosi
- Descrizione: Malattia del Sangue in cui la forma dei Globuli rossi, dalla caratteristica forma a disco biconcavo, diventa sferica (sferociti). Questi si reperiscono nella malattia di Minkowski-Chauffard e in alcune anemie. Sebbene gli sferociti possiedano un'area superficiale inferiore a quella degli eritrociti normali, essi svolgono comunque adeguatamente il loro ruolo, ma risultano più fragili.
- Foglietto embrionale: Mesoderma recente. Fase attiva.
- Senso biologico [!]: Migliorare la struttura della Famiglia.
- Attivazione [!]: Attivazione di inadeguatezza nel contesto della "sfera" familiare in cui ci si sente fragili e spinti a modificare la propria apparenza. “Per essere accettato nel Clan devo cambiare”.
- Riflessioni: Non riesco ad essere me stesso in questa famiglia? Devo sempre adattarmi alle pretese del clan?
Se ritieni che questo servizio abbia un valore, puoi contribuire con una piccola donazione


Giorgio Beltrammi
Bio-Pedia III
648 pagine B/N, 1683 termini circa
Formato A5 (148 x 210 mm.)
Acquista →